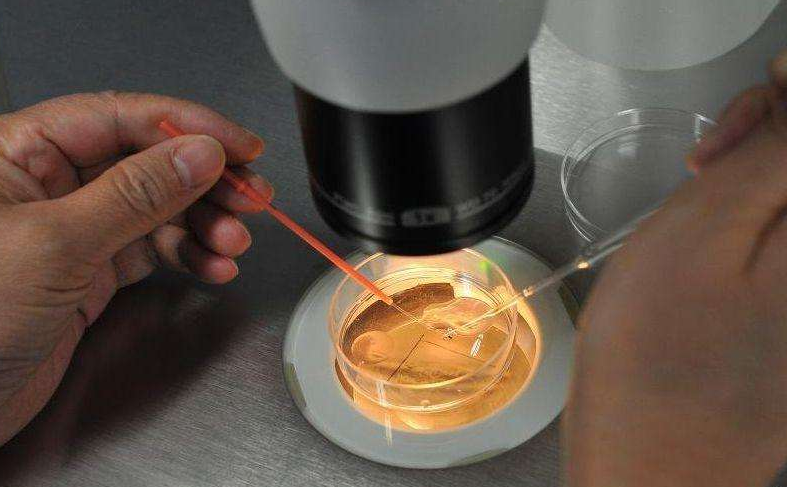

中国"首例"试管婴儿生子!这篇报道很快引起人们的热议。特别是一些年龄大的人群,"试管婴儿"这几个字听上去,难道宝宝是在试管里面出生的吗?那就带着这个问题一起往下看看吧!
随着社会的不断发展,人们的生活水平也逐年提高,衣食住行也不同往日,尤其是饮食上的"多样化",导致当下社会不孕不育的女性群体越来越多。为了满足一些想要成为爸爸妈妈人们的心愿,针对这一问题,就开始出现了试管婴儿这一项操作。

就像一些女明星,范玮琪、张庭、黎姿、刘若英等等,作为公众人物,因为各种原因,生孩子的年龄往往比较偏大,都会选择做试管婴儿。所以,经过这些成功的事例,相信大家对试管婴儿的各种担心可以放下了。

就是医生采取人工的方法,让卵细胞和男性的JZ在人身体外受精,早期在进行胚胎发育过后,然后再移植到女性子宫里成长发育,这样生下来的宝宝,就是试管婴儿。
到目前,这种先进的技术已经被更多地女性接受,不再像以前一样被人们因为毫无依据而心生歧视。

医生考虑过后觉得张先生的症状属于"梗阻性无JZ症"建议做试管婴儿,夫妻俩人也在医生的配合下,开始了一系列的术前检查,像女性的药物促排、取卵等等。
取卵当天,医生给掌张先生进行了GW取精,这种方式取出的精子量比较少,方便形成的优质胚胎然后再进行移植,其他多余的可以冷冻保存,以后也可以继续解冻移植,这样就避免了再次用药促排、取卵和取精带来的手术性创伤。
在解冻然后移植的第14天左右,经过检查,医生确定张先生老婆受孕,俩人也很开心,到如今已经顺利、成功的生下一名男婴。在一家人沉浸在喜悦当中的时候,女方的婆婆把张先生叫到一边,说道:"一直听你们说试管婴儿,怕影响到你们,也一直没问。试管?孩子难道是在试管里面培育出生的?这也太荒谬了,起初也没当回事,但现在孩子生下来,这是你俩亲生的吗?"

张先生笑着说道:"肯定是呀,怎么会有这种"偏见"呢?试管婴儿是把男方的JZ和女方的LZ提取出来,在体外受精后,再把很小的胚胎放进女方的子宫内,慢慢的成长发育,到后面就跟其他正常怀孕一样了"。
听得似懂非懂的样子,其他人过来也解释说道,甚至拿出身边事物挨个举例,婆婆这才打消了心中的疑虑,也在心底里暗暗夸赞技术的先进,给家人带来了福音。

现实生活中,其实像上述婆婆一样心理的人不在少数,虽然试管婴儿被大多女性群体所接受,但是各种说法也都一直存在!
试管婴儿和普通正常的婴儿有什么区别?这些你可能不知道1、怀孕的方式
指的是在胚胎发育之前的阶段,但据科学角度分析,试管婴儿的优势好过普通的婴儿。它的寿命也更长一些,因为可以提前发现健康方面的问题,这是普通怀孕做不到的。
2、受精卵的差别
胎儿发育得健康程度,取决于受精卵的质量。
如果卵细胞或者JZ两者中的任何一方有问题,都会导致女性在怀孕过程中出现问题,像一些自然流产的孕妇,大多是因为受精卵质量比较低,所以"优胜劣汰"没能保住,或者像一些具有遗传病史的,可以提前筛选出健康的JZ。
3、孩子的智力
大多数人总认为试管婴的智力会比普通婴儿低,无稽之谈!它并不是在试管里面成长,而是胚胎先在试管里面生成,经历3-5天左右的时间,再把胚胎从试管里移植到女性子宫,再接下来,怀孕的过程和普通婴儿一样,孩子的智力自然就跟普通生育的孩子一样,就没有试管婴儿智力比较低这种说法了。

每对年轻的父母都希望拥有属于自己的孩子,但往往也会因为各种问题导致无法生育,而现在,试管婴儿成功的事例出来了,大家也可以不用歧视的眼光对待,因为孩子的出生,和普通婴儿是一样的,甚至更有优势。